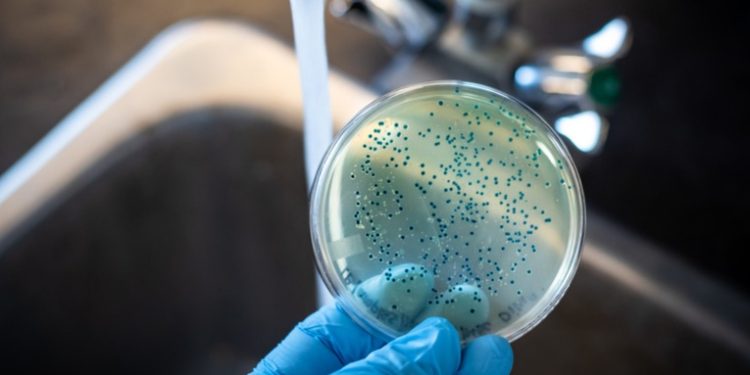
Encuentran bacterias carnívoras causantes de enfermedades en las aguas costeras de EE.UU.

2023-10-18
Nuevo Mundo – 96.1
Un estudio científico, realizado por investigadores de varias instituciones de EE.UU., detectó varias especies de bacterias patógenas, algunas de ellas carnívoras, en muestras de agua y ostras del condado de Lee en Florida, la región costera que fue devastada por el huracán Ian en septiembre de 2022.La detección de los patógenosEl análisis de la secuenciación genómica de unas muestras obtenidas en octubre del pasado año, y datos satelitales y ambientales revelaron la presencia de las especies ´Vibrio parahaemolyticus´ y ´Vibrio vulnificus´. «Nos sorprendió mucho poder detectar, sin ninguna dificultad, la presencia de estos patógenos», comentó la autora principal del estudio publicado en mBio, Rita Colwell, profesora de la Universidad de Maryland.Colwell y sus coautores señalaron que, si bien analizaron solo un número limitado de muestras, sus hallazgos ilustran el potencial del análisis genético, los datos ambientales y la teledetección para mejorar la salud pública.Los hallazgos del estudio corresponden con un aumento del número de infectados por la bacteria ´Vibrio vulnificus´ en el estado de Florida en octubre de 2022. Según el Departamento de Salud de Florida, en el condado de Lee, que tuvo el mayor número de casos en el estado, hubo 11 muertes relacionadas con estas bacterias.Las secuelas de IanSegún los investigadores, varias condiciones durante y después del huracán Ian favorecieron el crecimiento de la bacteria ´Vibrio vulnificus´. En particular, las inundaciones, los cambios en la temperatura de la superficie del mar y las altas densidades de fitoplancton, y posteriormente de zooplancton en el área afectada, son señalados como elementos de riesgo. En los lugares con floraciones de plancton, los investigadores encontraron una abundancia de las bacterias.El cambio climático y las enfermedadesLas autoridades sanitarias explicaron que esta bacteria generalmente se reproduce en aguas costeras cálidas, durante los meses de verano. Asimismo, comentaron que se ha registrado un mayor número de infecciones en los estados cercanos al golfo de México. Los expertos creen que el calentamiento de los océanos impulsará tormentas tan destructivas como Ian, por lo que las comunidades costeras podrían sufrir más infecciones en el futuro.»Estos Vibrios suelen crecen bien entre 15 y 40 grados Celsius, por lo que a medida que la temperatura aumenta, su tiempo de generación se acorta y se dividen cada vez más rápido», señaló Colwell. «El calentamiento del agua de mar, que se mezcla con el agua dulce, creando salinidades óptimas, realmente mejora el crecimiento de Vibrios, por lo que es una preocupación muy seria», subrayó.»En el lado positivo, sabiendo que estas infecciones están asociadas a la mayor variabilidad de un clima cambiante, tal vez ahora sea el momento de desarrollar mecanismos para comprenderlo y mitigarlo», afirmó Colwell. «El cambio climático y las inundaciones están claramente relacionados con las enfermedades infecciosas y debemos tomárnoslo en serio».
Un estudio científico, realizado por investigadores de varias instituciones de EE.UU., detectó varias especies de bacterias patógenas, algunas de ellas carnívoras, en muestras de agua y ostras del condado de Lee en Florida, la región costera que fue devastada por el huracán Ian en septiembre de 2022.
El análisis de la secuenciación genómica de unas muestras obtenidas en octubre del pasado año, y datos satelitales y ambientales revelaron la presencia de las especies ´Vibrio parahaemolyticus´ y ´Vibrio vulnificus´. «Nos sorprendió mucho poder detectar, sin ninguna dificultad, la presencia de estos patógenos», comentó la autora principal del estudio publicado en mBio, Rita Colwell, profesora de la Universidad de Maryland.
Colwell y sus coautores señalaron que, si bien analizaron solo un número limitado de muestras, sus hallazgos ilustran el potencial del análisis genético, los datos ambientales y la teledetección para mejorar la salud pública.
Los hallazgos del estudio corresponden con un aumento del número de infectados por la bacteria ´Vibrio vulnificus´ en el estado de Florida en octubre de 2022. Según el Departamento de Salud de Florida, en el condado de Lee, que tuvo el mayor número de casos en el estado, hubo 11 muertes relacionadas con estas bacterias.
Según los investigadores, varias condiciones durante y después del huracán Ian favorecieron el crecimiento de la bacteria ´Vibrio vulnificus´. En particular, las inundaciones, los cambios en la temperatura de la superficie del mar y las altas densidades de fitoplancton, y posteriormente de zooplancton en el área afectada, son señalados como elementos de riesgo. En los lugares con floraciones de plancton, los investigadores encontraron una abundancia de las bacterias.
Las autoridades sanitarias explicaron que esta bacteria generalmente se reproduce en aguas costeras cálidas, durante los meses de verano. Asimismo, comentaron que se ha registrado un mayor número de infecciones en los estados cercanos al golfo de México. Los expertos creen que el calentamiento de los océanos impulsará tormentas tan destructivas como Ian, por lo que las comunidades costeras podrían sufrir más infecciones en el futuro.
«Estos Vibrios suelen crecen bien entre 15 y 40 grados Celsius, por lo que a medida que la temperatura aumenta, su tiempo de generación se acorta y se dividen cada vez más rápido», señaló Colwell. «El calentamiento del agua de mar, que se mezcla con el agua dulce, creando salinidades óptimas, realmente mejora el crecimiento de Vibrios, por lo que es una preocupación muy seria», subrayó.
«En el lado positivo, sabiendo que estas infecciones están asociadas a la mayor variabilidad de un clima cambiante, tal vez ahora sea el momento de desarrollar mecanismos para comprenderlo y mitigarlo», afirmó Colwell. «El cambio climático y las inundaciones están claramente relacionados con las enfermedades infecciosas y debemos tomárnoslo en serio».